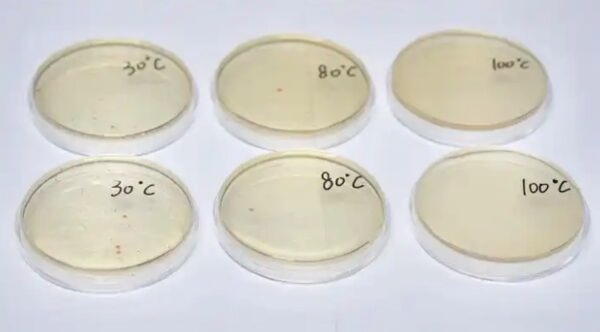
d8658790-a0b8c90b6b224.jpg

จีนทดลองให้แล้ว ใช้ "น้ำร้อนมาลวกถ้วยชาม" ฆ่าเชื้อได้จริงไหม? วิทยาศาสตร์ให้คำตอบชัด
-2466da6ce77ec.jpg?imageMogr2/quality/80/format/jpg/crop/1200x700)
เผยผลทดลอง "น้ำร้อนมาลวกถ้วยชาม" ฆ่าเชื้อได้จริงไหม? สรุปสั้นๆ น้ำต้องเดือด-ลวกนาน
คนไทยและคนจีนโดยเฉพาะในมณฑลกวางตุ้ง มักมีนิสัยการนำ "น้ำร้อนมาลวกถ้วยชาม" ก่อนรับประทานอาหารนอกบ้านเพื่อความสบายใจ แต่ที่ผ่านมากลับมีข้อสงสัยมาตลอดว่าวิธีการนี้สามารถฆ่าเชื้อโรคได้จริงหรือไม่
ล่าสุด ศูนย์ทดสอบในมณฑลเจ้อเจียงได้เผยผลการทดลองทางวิทยาศาสตร์ที่ให้คำตอบที่ชัดเจนในเรื่องนี้
สำนักข่าว ETtoday รายงานว่า ศูนย์ตรวจสอบและกักกันแห่งอำเภอถงลู่ มณฑลเจ้อเจียง ประเทศจีน ได้ทำการทดลองเพื่อพิสูจน์ประสิทธิภาพของการลวกจาน
โดยนำถ้วยที่มีระดับความปนเปื้อนของเชื้อแบคทีเรียเท่ากันจำนวน 6 ใบ มาจำลองสถานการณ์การลวกจานด้วยอุณหภูมิน้ำที่แตกต่างกันคือ 30 องศาเซลเซียส, 80 องศาเซลเซียส และ 100 องศาเซลเซียส พร้อมเปรียบเทียบระหว่าง "การลวกผ่านอย่างรวดเร็ว" กับ "การแช่ทิ้งไว้นาน 2 นาที"
ผลการทดลองเผย: อุณหภูมิและเวลาคือหัวใจสำคัญ
จากการเก็บข้อมูลตัวอย่างทั้ง 6 กลุ่ม พบว่าอุณหภูมิของน้ำยิ่งสูงและระยะเวลาในการลวกยิ่งนาน ประสิทธิภาพในการฆ่าเชื้อก็จะยิ่งดีขึ้น โดยมีรายละเอียดที่น่าสนใจดังนี้:
- น้ำเดือด 100 องศาเซลเซียส (แช่นาน 2 นาที): พบเชื้อแบคทีเรียตกค้างน้อยที่สุดและให้ผลดีที่สุดในการฆ่าเชื้อ
- น้ำร้อน 80 องศาเซลเซียส: สามารถฆ่าเชื้อได้ในระดับหนึ่ง แต่ยังไม่เทียบเท่าน้ำเดือดจัด
- น้ำอุ่น 30 องศาเซลเซียส (ลวกผ่าน): ผลการฆ่าเชื้อแทบจะเป็นศูนย์ หรือแทบไม่มีความแตกต่างจากการไม่ลวกเลย
ผลการทดลองสรุปได้ว่า การลวกจานก่อนทานอาหารช่วยลดเชื้อโรคได้ "บางส่วน" แต่ต้องอาศัยเงื่อนไขที่เหมาะสมคือ "น้ำต้องร้อนจัดและใช้เวลาแช่ที่นานพอ" เนื่องจากเชื้อแบคทีเรียแต่ละชนิดมีความทนทานต่อความร้อนต่างกัน การลวกเพียงผ่านๆ ด้วยน้ำที่เริ่มเย็นลงจึงไม่สามารถฆ่าเชื้อโรคได้อย่างแท้จริง

คำแนะนำเพื่อสุขอนามัยที่มั่นใจกว่า
แม้การลวกจานในร้านอาหารจะเป็นวิธีที่ช่วยเพิ่มความมั่นใจในระดับหนึ่ง แต่ผู้เชี่ยวชาญแนะนำว่าหากต้องการความสะอาดสูงสุด ควรใช้วิธีนำภาชนะไปต้มในน้ำเดือดเพื่อฆ่าเชื้อเป็นประจำ หรือใช้เครื่องอบฆ่าเชื้อโดยเฉพาะ (Sterilizer) เพื่อสุขอนามัยที่สมบูรณ์แบบ
สำหรับผู้ที่ทานอาหารนอกบ้าน หากน้ำร้อนที่ทางร้านจัดเตรียมมาให้ไม่ร้อนจัดพอ หรือมีปริมาณน้อย การเช็ดภาชนะด้วยทิชชู่สะอาดหรือแอลกอฮอล์ฟู้ดเกรดอาจเป็นอีกทางเลือกที่ช่วยเสริมความมั่นใจได้มากกว่าการลวกด้วยน้ำอุ่นเพียงอย่างเดียว
 ดาวน์โหลดสนุกแอปฟรี
ดาวน์โหลดสนุกแอปฟรี-eaba3b16918c4.jpg?imageMogr2/quality/80/format/webp/crop/350x197)



